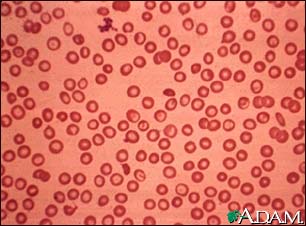
Thalassemia minor

Medical Encyclopedia
Thalassemia minor
Thalassemia minor is an inherited form of hemolytic anemia that is less severe than thalassemia major. This blood smear from an individual with thalassemia shows small (microcytic), pale (hypochromic), variously-shaped (poikilocytosis) red blood cells. These small red blood cells (RBCs) are able to carry less oxygen than normal RBCs.
Update Date: 5/3/2006
Updated by: Michael C. Milone, M.D., Ph.D., Department of Pathology and Laboratory Medicine, University of Pennsylvania Medical Center, Philadelphia, PA.
The information provided herein should not be used during any medical emergency or for the diagnosis or treatment of any medical condition. A licensed physician should be consulted for diagnosis and treatment of any and all medical conditions. Call 911 for all medical emergencies. Links to other sites are provided for information only -- they do not constitute endorsements of those other sites. Copyright 1997-2009, A.D.A.M., Inc. Any duplication or distribution of the information contained herein is strictly prohibited.